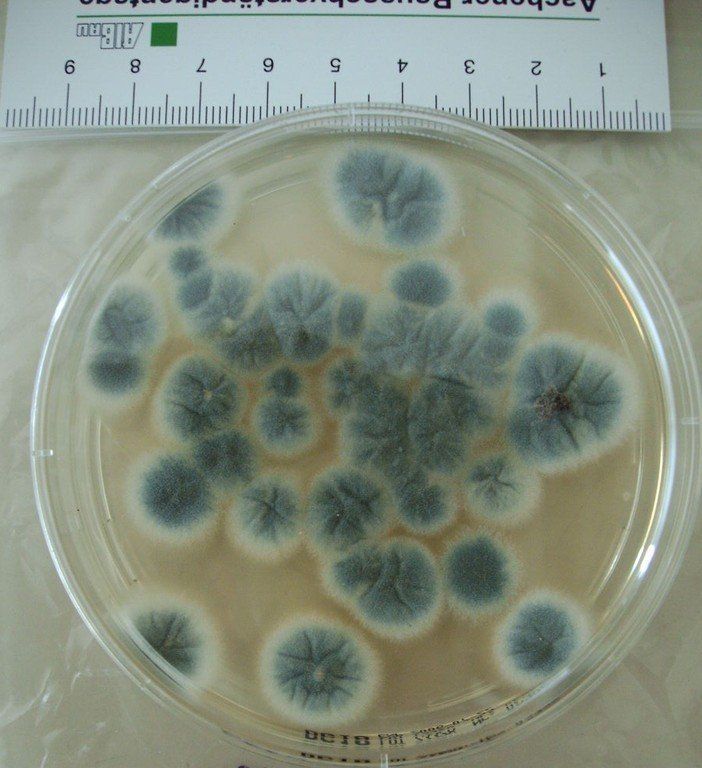

mold
Biological stress caused by indoor mold
Mold is part of our natural environment. In the course of evolution, over millions of years, fungi have adapted ideally to growing on existing biomass such as wood. The biomass is decomposed and broken down into inorganic substances, which serve as an important nutrient basis for other living beings such as plants. Molds are therefore ideal "recyclers". Indoors, on the other hand, mold is very undesirable. To multiply, mold releases millions of tiny spores that contaminate the air we breathe. Likewise, the air is already unhealthy contaminated by fragments of these fungi.
This can trigger and promote a large number of diseases, which, however, are often misdiagnosed medically: • allergies (third most important allergen after pollen and mites) • respiratory diseases (cough, runny nose) • eye inflammation • headaches • irritation of the mucous membranes • infections or poisoning (rare) ( through contact with mycotoxins produced by mold) Often the causes of these diseases cannot be identified due to a lack of interior diagnosis and therefore only symptoms and not causes can be combated. There is a particular risk potential for: • Asthmatics • Allergy sufferers • People with restricted lung function • Immunosuppressed people • Babies and small children • Elderly people Disease-causing molds usually occur in damp areas of the house that are insufficiently ventilated. • • We would be happy to draw up a renovation concept for you and help you with the unequivocal assessment of mold infestation in living areas.